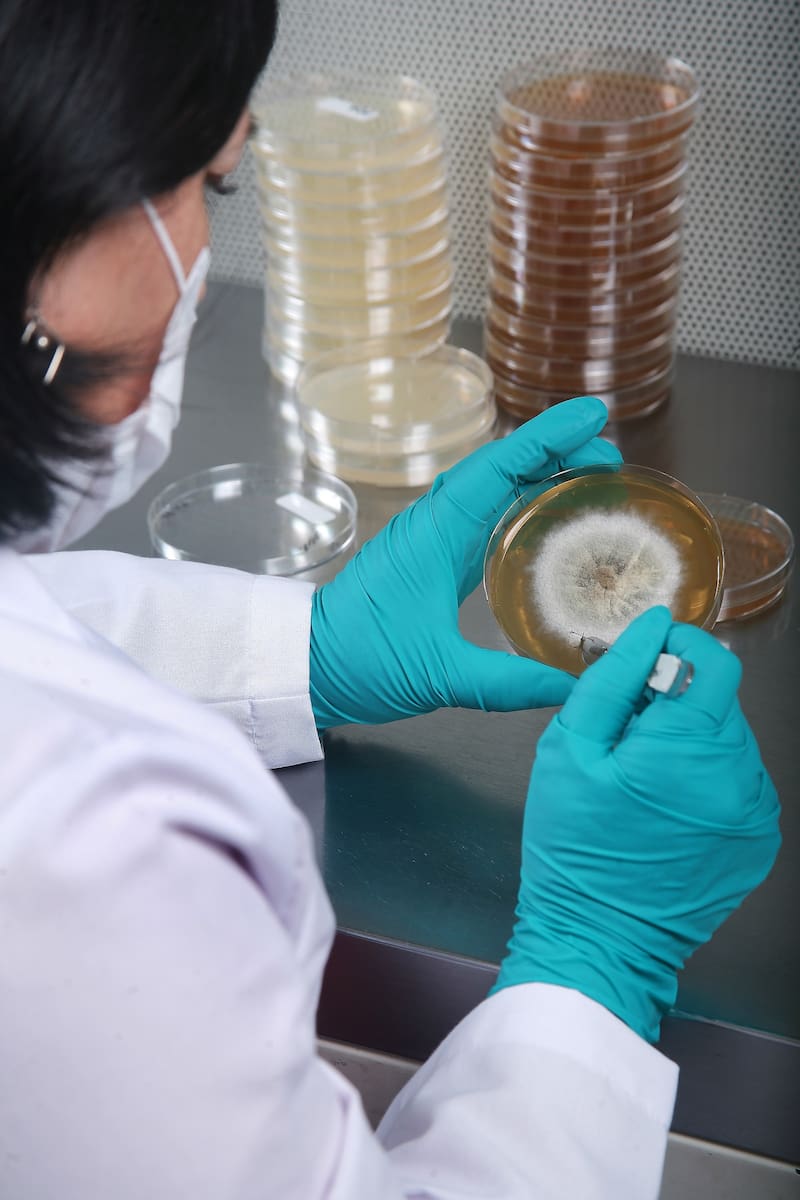

BIOFOREST: La apuesta de ARAUCO por la ciencia e innovación de cara a la crisis climática
Su centro de excelencia e investigación ‘Bioforest’ realiza un trabajo colaborativo con universidades y centros tecnológicos con el fin de impulsar proyectos que aminoren la crisis climática. Su desafío: alcanzar la meta de cero residuos al 2030.


El cambio climático, la destrucción de ecosistemas, la pérdida de biodiversidad y la contaminación que produce el ser humano, han sido solo algunos de los factores que han ido deteriorando nuestro planeta.
Según un estudio realizado por la Convención de las Naciones Unidas de Lucha contra la Desertificación (CLD), llamado ‘Perspectiva global de la tierra 2′, señala que hasta el 40% de la tierra del planeta está degradada, lo que afecta a la mitad de la humanidad.
El informe advierte que: “En la historia reciente, nunca se había enfrentado la humanidad a tal variedad de riesgos y peligros conocidos y desconocidos que interactúan en un mundo hiperconectado que cambia rápidamente. No podemos permitirnos subestimar la escala y las repercusiones de estas amenazas existenciales”.
Una situación que está generando mayor consciencia en la población mundial y también en las empresas. La sostenibilidad está ganando protagonismo en las agendas corporativas de las compañías de todo el mundo. Así lo reveló un estudio realizado por IBM, quien encuestó a más de 3.000 CEOs de varios países y descubrió que la mitad de los encuestados considera a la sostenibilidad como una prioridad máxima para sus organizaciones, lo que representa un aumento frente al 37% de 2021.
En Chile, ARAUCO es parte de las empresas que se han comprometido activamente con la crisis climática y el desarrollo sostenible. A través de un robusto plan, la compañía ha logrado certificar por tercer año consecutivo su carbono neutralidad y activar un plan que permitirá reducir 1 millón de toneladas de CO2 al 2030.
Para llevar a cabo esto, Sebastián Fernández, gerente de investigación y desarrollo de ARAUCO, señala que la ciencia, investigación y el desarrollo son esenciales para garantizar la sostenibilidad en el largo plazo. Es así como surge Bioforest, un centro de estudio que lleva 30 años realizando investigación y desarrollo de flora y fauna dentro de los bosques, trabajo colaborativo que ARAUCO realiza junto a universidades y centros tecnológicos nacionales e internacionales.
“A través de nuestro centro de investigación, aplicamos ciencia y tecnología a necesidades prioritarias de los negocios con foco en productividad y sostenibilidad, además de generar permanentemente un mejor entendimiento sobre las especies que se encuentran en nuestro patrimonio”.
Fernández agrega también que: “Desde la compañía existe la fuerte convicción de que la mejor manera de combatir el cambio climático es con más naturaleza. El mundo ha sido claro y nos ha presentado desafíos complejos que requieren compromisos reales que cumplan con las exigencias de la urgencia climática. En ese sentido, los árboles y la madera son claves para avanzar en esta problemática”.
Bioforest: brazo científico y tecnológico
Bioforest mantuvo en un comienzo un enfoque I+D pero con el tiempo se fue expandiendo desde el bosque a los negocios de celulosa, paneles y maderas. Junto con este crecimiento, la institución incorporó a investigadores de distintas universidades, quienes formaban parte de redes científicas, académicas y tecnológicas tanto en Chile como en otros lugares del mundo.
Hoy ARAUCO ha robustecido la red de centros tecnológicos con los que trabaja en la búsqueda de soluciones y propuestas frente a los temas vinculados con el ecosistema y con la necesidad de gestionarlo en forma rentable y sostenible al mismo tiempo.
Actualmente, Bioforest cuenta con un equipo de más de 50 investigadores que están en constante búsqueda y desarrollo de tecnologías y procesos, los cuales son evaluados según las prioridades y valor estratégico para el negocio. “En esta búsqueda se mantiene un contacto muy activo con distintas universidades en Chile y el mundo”, explica Fernández.
El resultado: mejoramiento de especies, productividad, carbono neutralidad, conservación y restauración ecológica, crisis hídrica y varios otros forman parte de una lista a la que cada día se añade un nuevo desafío.
Fernández explica también que el vínculo y el trabajo con casas de estudio superiores se da a través de apoyo a trabajos de tesis y prácticas profesionales, y también cuando los investigadores de Bioforest cursan sus doctorados. “Lo cual no solo permite contar con profesionales altamente calificados, sino también mantener un contacto directo con universidades en Chile y el mundo”, precisa.

Desafíos que se vienen
Pese a que la pandemia paralizó muchas áreas del país, el trabajo colaborativo entre ARAUCO y el mundo académico pudo continuar sin que los proyectos más relevantes que estaban en curso se vieran afectados en forma significativa.
Como parte de ese esfuerzo que han realizado los equipos, Fernández destaca un importante estudio sobre el comportamiento de plantaciones forestales y bosque nativo, orientado a aumentar la adaptabilidad de ciertas especies a condiciones climáticas más extremas. “Esto con el fin de estar mejor preparados para los desafíos que representa el cambio climático”, sostiene.
Fernández también comparte que se trabaja permanentemente en el monitoreo de especies y conservación de la biodiversidad, así como en estudios que permiten entender en más detalle el comportamiento de cuencas de agua y en la evaluación de nuevas tecnologías para la reducción de la huella de CO2.

Todas las investigaciones que realizan en Bioforest van en línea con los importantes desafíos medioambientales que se ha planteado la compañía para los próximos años. “En la reciente COP26 en Glasgow, anunciamos una importante cartera de proyectos de Acción Climática que permitirán la disminución de 1 millón de toneladas de CO2 al 2030. En ese sentido, uno de los compromisos más destacados tiene relación con la restauración de 50 mil hectáreas de bosque nativo, meta que estará en línea con las Contribuciones Determinadas a Nivel Nacional (NDC), además de anunciar que seguiremos comprometidos con la no extinción de especies emblemáticas como el zorro y ranita de Darwin, y la protección de especies como las araucarias y el ruil”, comparte Fernández.
De las tareas que se vienen a futuro se encuentra el compromiso de alcanzar la meta de cero residuos al 2030 y conversaciones de ARAUCO con académicos de diferentes universidades nacionales para desarrollar un modelo de mayor colaboración en temas tan relevantes como cambio climático, ciclo de carbono, agua y biodiversidad, por nombrar algunos. “Hemos visto que hay grandes capacidades técnicas, y estamos convencidos de que trabajando juntos vamos a ser capaces de acelerar las líneas de investigación que tenemos en torno a estos temas, para luego aplicarlas a distintas áreas de nuestro negocio”, puntualiza Sebastián Fernández.

COMENTARIOS
Para comentar este artículo debes ser suscriptor.
Lo Último
Lo más leído
Plan digital + LT Beneficios por 3 meses
Comienza el año bien informado y con beneficios para ti ⭐️$3.990/mes SUSCRÍBETE













